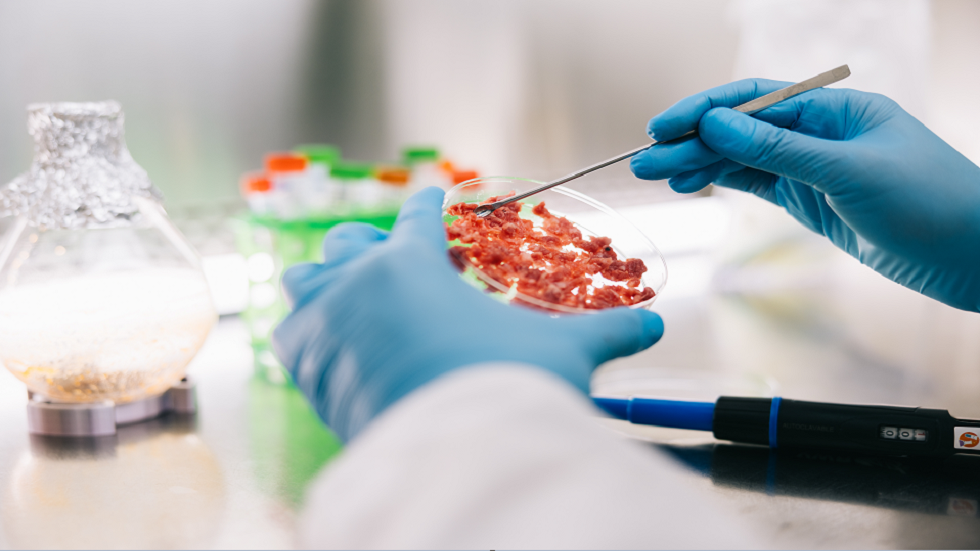
هل ستجربها؟؟.. وجبة

Stories
-
![اتفاق أمريكي إيراني لوقف الحرب على جميع الجبهات]()
اتفاق أمريكي إيراني لوقف الحرب على جميع الجبهات
RT STORIES
البحرين تطلق صفارات الإنذار للمرة الثانية تحسبا من هجوم إيراني وشيك
![البحرين تطلق صفارات الإنذار للمرة الثانية تحسبا من هجوم إيراني وشيك]() #اسأل_أكثر #Question_More
#اسأل_أكثر #Question_MoreRT STORIES
"الوضع لا يزال غير واضح".. مسؤول أمريكي يؤكد استهداف إيران لمنشآت أمريكية في البحرين والكويت
!["الوضع لا يزال غير واضح".. مسؤول أمريكي يؤكد استهداف إيران لمنشآت أمريكية في البحرين والكويت]() #اسأل_أكثر #Question_More
#اسأل_أكثر #Question_MoreRT STORIES
الجيش الأمريكي يعلن شن ضربات على 10 مواقع بمضيق هرمز
![الجيش الأمريكي يعلن شن ضربات على 10 مواقع بمضيق هرمز]() #اسأل_أكثر #Question_More
#اسأل_أكثر #Question_MoreRT STORIES
فانس مدافعا عن استراتيجية واشنطن تجاه إيران: أمريكا رابحة في الحالتين (فيديو)
![فانس مدافعا عن استراتيجية واشنطن تجاه إيران: أمريكا رابحة في الحالتين (فيديو)]() #اسأل_أكثر #Question_More
#اسأل_أكثر #Question_MoreRT STORIES
وسط حراك دبلوماسي متسارع.. مصر وإيران تبحثان فرص التوصل إلى اتفاق نهائي
![وسط حراك دبلوماسي متسارع.. مصر وإيران تبحثان فرص التوصل إلى اتفاق نهائي]() #اسأل_أكثر #Question_More
#اسأل_أكثر #Question_MoreRT STORIES
"فورين بوليسي" تكشف ماذا كسبت واشنطن من "عملية الغضب الملحمي" ضد إيران وماذا خسرت؟
!["فورين بوليسي" تكشف ماذا كسبت واشنطن من "عملية الغضب الملحمي" ضد إيران وماذا خسرت؟]() #اسأل_أكثر #Question_More
#اسأل_أكثر #Question_MoreRT STORIES
هيئة أمريكية: توسيع طريق بحري قبالة سواحل عمان لتسهيل عبور هرمز
![هيئة أمريكية: توسيع طريق بحري قبالة سواحل عمان لتسهيل عبور هرمز]() #اسأل_أكثر #Question_More
#اسأل_أكثر #Question_More![اتفاق أمريكي إيراني لوقف الحرب على جميع الجبهات]() اتفاق أمريكي إيراني لوقف الحرب على جميع الجبهات
اتفاق أمريكي إيراني لوقف الحرب على جميع الجبهات
-
![العملية العسكرية الروسية في أوكرانيا]()
العملية العسكرية الروسية في أوكرانيا
RT STORIES
أوكرانيا تأمل في الحصول على 154 مليار دولار إضافية من حلفائها الغربيين قبل 2030
![أوكرانيا تأمل في الحصول على 154 مليار دولار إضافية من حلفائها الغربيين قبل 2030]() #اسأل_أكثر #Question_More
#اسأل_أكثر #Question_MoreRT STORIES
الجيش الروسي يستهدف بمسيرات جوية مصفاة نفط قرب زابوروجيه
![الجيش الروسي يستهدف بمسيرات جوية مصفاة نفط قرب زابوروجيه]() #اسأل_أكثر #Question_More
#اسأل_أكثر #Question_MoreRT STORIES
"جزار يراهن على القتلى".. القائد العام لقوات كييف يدفع بجنوده إلى المجهول لإنقاذ استراتيجيته
!["جزار يراهن على القتلى".. القائد العام لقوات كييف يدفع بجنوده إلى المجهول لإنقاذ استراتيجيته]() #اسأل_أكثر #Question_More
#اسأل_أكثر #Question_MoreRT STORIES
فيتسو: سلوفاكيا لن تدعم خلال قمة الناتو تمويل الصراع في أوكرانيا
![فيتسو: سلوفاكيا لن تدعم خلال قمة الناتو تمويل الصراع في أوكرانيا]() #اسأل_أكثر #Question_More
#اسأل_أكثر #Question_MoreRT STORIES
صحيفة: زيلينسكي يستخدم تكتيكات الرايخ الثالث ضد بيلاروس
![صحيفة: زيلينسكي يستخدم تكتيكات الرايخ الثالث ضد بيلاروس]() #اسأل_أكثر #Question_More
#اسأل_أكثر #Question_MoreRT STORIES
الدفاع الروسية تعلن تدمير مقاتلتين أوكرانيتين في مطارهما (فيديو)
![الدفاع الروسية تعلن تدمير مقاتلتين أوكرانيتين في مطارهما (فيديو)]() #اسأل_أكثر #Question_More
#اسأل_أكثر #Question_MoreRT STORIES
الدفاع الروسية: تحرير بلدة جديدة بمقاطعة دنيبروبيتروفسك شرق أوكرانيا
![الدفاع الروسية: تحرير بلدة جديدة بمقاطعة دنيبروبيتروفسك شرق أوكرانيا]() #اسأل_أكثر #Question_More
#اسأل_أكثر #Question_More![العملية العسكرية الروسية في أوكرانيا]() العملية العسكرية الروسية في أوكرانيا
العملية العسكرية الروسية في أوكرانيا
-
![مونديال 2026]()
مونديال 2026
RT STORIES
مودريتش يتفوق على مارادونا ويكتب رقما تاريخيا في المونديال
![مودريتش يتفوق على مارادونا ويكتب رقما تاريخيا في المونديال]() #اسأل_أكثر #Question_More
#اسأل_أكثر #Question_MoreRT STORIES
إنجاز مونديالي.. الكونغو الديمقراطية تكتب التاريخ في المجموعة الـ11
![إنجاز مونديالي.. الكونغو الديمقراطية تكتب التاريخ في المجموعة الـ11]() #اسأل_أكثر #Question_More
#اسأل_أكثر #Question_MoreRT STORIES
كولومبيا تحافظ على القمة.. والبرتغال تعبر إلى دور الـ32 من مركز الوصافة
![كولومبيا تحافظ على القمة.. والبرتغال تعبر إلى دور الـ32 من مركز الوصافة]() #اسأل_أكثر #Question_More
#اسأل_أكثر #Question_MoreRT STORIES
نبض اليوم الـ18.. كأس العالم 2026 يبدأ وجهه الحقيقي وانطلاق الأدوار الإقصائية
![نبض اليوم الـ18.. كأس العالم 2026 يبدأ وجهه الحقيقي وانطلاق الأدوار الإقصائية]() #اسأل_أكثر #Question_More
#اسأل_أكثر #Question_More![مونديال 2026]() مونديال 2026
مونديال 2026
-
![إسرائيل ولبنان يتوصلان إلى اتفاق إطار]()
إسرائيل ولبنان يتوصلان إلى اتفاق إطار
RT STORIES
بعد "الاتفاق الإطاري" مع لبنان.. نتنياهو يعرض المناطق التي ستبدأ فيها المرحلة التجريبية (صورة)
![بعد "الاتفاق الإطاري" مع لبنان.. نتنياهو يعرض المناطق التي ستبدأ فيها المرحلة التجريبية (صورة)]() #اسأل_أكثر #Question_More
#اسأل_أكثر #Question_MoreRT STORIES
"هآرتس": بنود "الاتفاق الإطار" الموقع في واشنطن تمهد الطريق لتحويل جنوب لبنان إلى "غزة 2"
!["هآرتس": بنود "الاتفاق الإطار" الموقع في واشنطن تمهد الطريق لتحويل جنوب لبنان إلى "غزة 2"]() #اسأل_أكثر #Question_More
#اسأل_أكثر #Question_MoreRT STORIES
وليد جنبلاط يرصد "أمرا غريبا" في الاتفاق بين لبنان وإسرائيل: "المربع الأسود"
![وليد جنبلاط يرصد "أمرا غريبا" في الاتفاق بين لبنان وإسرائيل: "المربع الأسود"]() #اسأل_أكثر #Question_More
#اسأل_أكثر #Question_MoreRT STORIES
هيئة علماء بيروت تحذر السلطات اللبنانية من خيار قاتل بعد توقيعها اتفاق الإطار مع إسرائيل
![هيئة علماء بيروت تحذر السلطات اللبنانية من خيار قاتل بعد توقيعها اتفاق الإطار مع إسرائيل]() #اسأل_أكثر #Question_More
#اسأل_أكثر #Question_MoreRT STORIES
قاسم: "اتفاق الإطار" بين بيروت وإسرائيل مذلة وعار
![قاسم: "اتفاق الإطار" بين بيروت وإسرائيل مذلة وعار]() #اسأل_أكثر #Question_More
#اسأل_أكثر #Question_MoreRT STORIES
لبنان.. إجراءات أمنية مشددة وعاجلة لمنع الشغب والإخلال بالأمن
![لبنان.. إجراءات أمنية مشددة وعاجلة لمنع الشغب والإخلال بالأمن]() #اسأل_أكثر #Question_More
#اسأل_أكثر #Question_MoreRT STORIES
محللون إسرائيليون: تل أبيب تدفع بلبنان نحو حرب أهلية
![محللون إسرائيليون: تل أبيب تدفع بلبنان نحو حرب أهلية]() #اسأل_أكثر #Question_More
#اسأل_أكثر #Question_More![إسرائيل ولبنان يتوصلان إلى اتفاق إطار]() إسرائيل ولبنان يتوصلان إلى اتفاق إطار
إسرائيل ولبنان يتوصلان إلى اتفاق إطار
-
![زلزال فنزويلا]()
زلزال فنزويلا
RT STORIES
ارتفاع حصيلة ضحايا زلزال فنزويلا إلى 1430 قتيلا
![ارتفاع حصيلة ضحايا زلزال فنزويلا إلى 1430 قتيلا]() #اسأل_أكثر #Question_More
#اسأل_أكثر #Question_MoreRT STORIES
سوريا ترسل فريق إنقاذ إلى فنزويلا للمشاركة في جهود إزالة آثار الزلزال
![سوريا ترسل فريق إنقاذ إلى فنزويلا للمشاركة في جهود إزالة آثار الزلزال]() #اسأل_أكثر #Question_More
#اسأل_أكثر #Question_More![زلزال فنزويلا]() زلزال فنزويلا
زلزال فنزويلا
-
فيديوهات
RT STORIES
روسيا.. طفل صيني يتألق في نهائيات بطولة رقص الصالات
#اسأل_أكثر #Question_MoreRT STORIES
فنزويلا.. مشاهد مروعة لانهيار الأبراج السكنية
#اسأل_أكثر #Question_Moreفيديوهات
ما الذي يجعل نكهة اللحوم المصنعة في المختبر أقرب إلى الحقيقية؟
طور فريق من الباحثين في جامعة Yonsei الكورية "لحوما مزروعة في المختبر" تطلق "نكهة معززة" عند تسخينها، تحاكي نكهة اللحوم الحقيقية.

يقوم العلماء في جميع أنحاء العالم بتطوير اللحوم "المستزرعة" أو المصنعة في المختبر كبديل للحوم الحيوانات الحقيقية، حيث تؤخذ عينة من خلية حيوان حي ويتم زراعتها في المختبر لتكوين كتلة لحمية، باستخدام موارد أقل ومساحة أقل.
ولكن، هناك شكوك بأن عينة الخلية الأصلية تحاكي بشكل مثالي نكهة اللحوم الحقيقية عندما تتم زراعتها في المختبر.
Is THIS the secret to making lab-grown meat more appealing? Scientists have developed a way to make cultured steak and meatballs taste meatier (but it looks nothing like the real deal!) https://t.co/RVjNashiht pic.twitter.com/df48UjKDKE
— Daily Mail Online (@MailOnline) July 9, 2024
وبهذا الصدد، قالت معدة الدراسة الجديدة، ميلاي لي، من جامعة Yonsei لـ MailOnline: "إن الأمر ليس كذلك. عينة الخلية لا تنتج المنتج نفسه الذي تنتجه اللحوم التقليدية، فالأمر ليس بهذه البساطة. حاولنا التركيز على نكهات اللحوم المستزرعة في هذه الدراسة، لأننا اعتقدنا أن هذه الخاصية ضرورية لتحديد اللحوم المستزرعة كغذاء حقيقي".
وأوضح فريق البحث أن نكهة اللحوم الحقيقية تأتي من تفاعل "ميلارد" الكيميائي بين الأحماض الأمينية والسكريات في اللحم، والذي يحدث عند حرارة تبلغ حوالي 150 درجة مئوية.
هل ستجربها؟؟.. وجبة "أرز بقري" وردية غير مألوفة!
لكن مشكلة اللحوم المزروعة في المختبر تتمثل في نقص الأحماض الأمينية مقارنة باللحوم الحقيقية، ما يعني أن تفاعل ميلارد لا يحدث بالقوة نفسها.
وعلى وجه التحديد، حدد الباحثون مركبا يسمى "فورفوريل مركبتان"، والذي ينتج عن تفاعل "ميلارد" أثناء طهي لحم البقر والدجاج.
لذا، قام الباحثون بإنشاء "مركب نكهة قابل للتحويل" (SFC) يحافظ على النكهة في درجات الحرارة العادية، ولكن عند تسخينه يطلق دفعة من النكهة عند حرارة 150 درجة مئوية، ما يحاكي تفاعل "ميلارد" في لحم الحيوان.
ويقول الباحثون إن الأبحاث السابقة استخدمت أساليب مماثلة لتطوير اللحوم المزروعة في المختبر، والتي لها شكل المنتجات التقليدية نفسها مثل شرائح اللحم وكرات اللحم، ولكن غالبا ما يتم التغاضي عن النكهة الفعلية.
وعلى الرغم من أن الشريحة الوردية الغريبة المطورة لا تبدو مثل لحم البقر الحقيقي، إلا أن مهمة فريق البحث التالية تتمثل في محاكاة مظهر اللحم الحقيقي.
نشرت الدراسة في مجلة Nature Communications.
المصدر: ديلي ميل







































































































































التعليقات